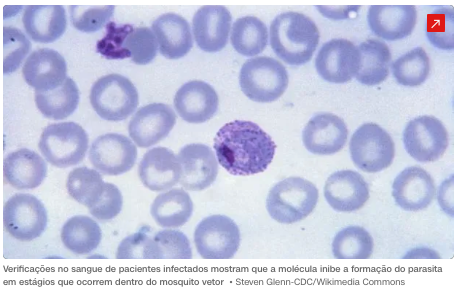
Composto sintético tem potencial para tratar malária e evitar transmissão

Fundada em 05 de maio de 2017, a APAS é uma entidade filantrópica em gestão de serviços de saúde e administração hospitalar.
faleconosco@apassaude.org
Links
- Horário de Atendimento
- Segunda-feira:
- Terça-feira:
- Quarta-feira:
- Quinta-feira:
- Sexta-feira:
- Sábado:
- Domingo:
- 9h às 17h
- 9h às 17h
- 9h às 17h
- 9h às 17h
- 9h às 17h
- Fechado
- Fechado
Associação de Proteção e Amparo à Saúde – APAS – CNPJ: 28.064.274/0001-63
Copyright © 2023 Todos os direitos reservados